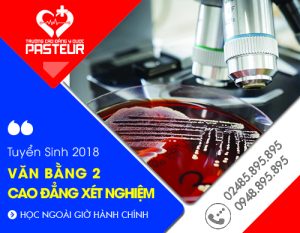

Lưu trữ danh mục: Thông tin tuyển sinh Y Dược
Đào tạo Văn bằng 2 Cao đẳng Xét nghiệm đảm bảo chất lượng tại Hà Nội
Hiện nay, có nhiều thí sinh băn khoăn không biết nên chuyển đổi Văn bằng...
Điều kiện xét tuyển vào Cao đẳng Điều dưỡng TPHCM năm 2018
Điều kiện để có thể đăng ký xét tuyển vào Cao đẳng Điều dưỡng TP...
Hồ sơ đăng ký nhập học Cao đẳng Điều dưỡng TPHCM năm 2018
Thí sinh có nguyện vọng học Cao đẳng Điều dưỡng TPHCM tại Cao đẳng Y...
Lý do Văn bằng 2 Cao đẳng Y Dược thu hút đông thí sinh theo học?
Với thuận lợi trong chương trình học cùng cơ hội việc làm khá tốt, Văn...
Lợi ích của chương trình học Văn bằng 2 Cao đẳng Dược
Học văn bằng 2 Cao đẳng Dược được biết tới là một trong nhiều chương...
Hồ sơ đăng ký học Liên thông Cao đẳng Dược TPHCM năm 2018
Đối với những thí sinh có nhu cầu học liên thông Cao đẳng Dược tại...
Sức hút mạnh mẽ thí sinh theo học của Liên thông Cao đẳng Dược
Trong những năm gần đây liên thông Cao đẳng Dược đang thu hút được một...
Những lợi thế của sinh viên khi cầm trên tay tấm bằng Cao đẳng Dược
Tình trạng thất nghiệp không còn là hiện tượng hiếm gặp đối với sinh viên...
Liên thông Cao đẳng Dược TPHCM năm 2018
Nâng cao trình độ để thích nghi với nhu cầu công việc và bắt kịp...
Cao đẳng Y Dược Pasteur TPHCM thông báo tuyển sinh Cao đẳng Hộ sinh năm 2018
Bắt đầu từ năm 2018, Trường Cao đẳng Y Dược Pasteur TPHCM chính thức thông...